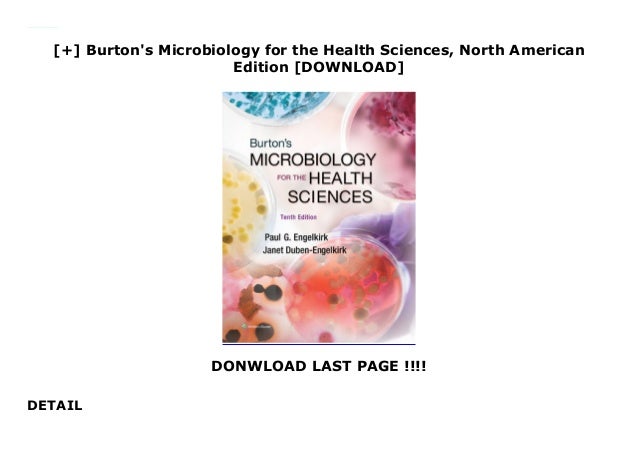

Burtons Microbiology For The Health Sciences North American Edition
 Burton S Microbiology For The Health Sciences North American
Burton S Microbiology For The Health Sciences North American
burtons microbiology for the health sciences north american edition
burtons microbiology for the health sciences north american edition is important information with HD images sourced from all websites in the world. Download this image for free by clicking "download button" below. If want a higher resolution you can find it on Google Images.
Note: Copyright of all images in burtons microbiology for the health sciences north american edition content depends on the source site. We hope you do not use it for commercial purposes.

 Burton S Microbiology For The Health Sciences North American
Burton S Microbiology For The Health Sciences North American
 Burton S Microbiology For The Health Sciences North American Editio
Burton S Microbiology For The Health Sciences North American Editio
 9781605476735 Burton S Microbiology For The Health Sciences
9781605476735 Burton S Microbiology For The Health Sciences
 Burton S Microbiology For The Health Sciences Paul Engelkirk
Burton S Microbiology For The Health Sciences Paul Engelkirk
 Pdf Burton S Microbiology For The Health Sciences North American
Pdf Burton S Microbiology For The Health Sciences North American
Burton S Microbiology For The Health Sciences North American Edi
Burton S Microbiology For The Health Sciences North American Edi
Download Burton S Microbiology For The Health Sciences North
 Burton S Microbiology For The Health Sciences North American
Burton S Microbiology For The Health Sciences North American
Full E Book Burton S Microbiology For The Health Sciences North
About For Books Burton S Microbiology For The Health Sciences
 Burton S Microbiology For The Health Sciences North American
Burton S Microbiology For The Health Sciences North American



